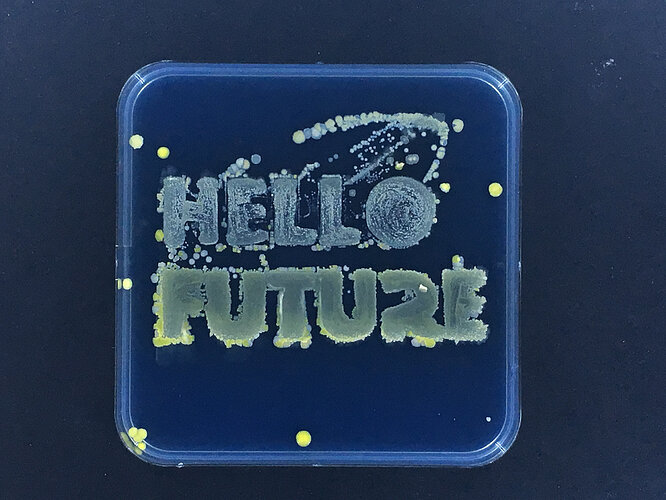

Intro-Biohacking&Bioink Workshopaaa:
English Version Below
Dies ist eine kurze Einführung in Biohacking und transdisziplinäres Design. De praktische Workshop konzentriert sich auf Biomaterialien, Hautbiom und Bioink.
Wir werden Biohacking, Materialwissenschaften mit Design Thinking und Rapid Prototyping kombinieren. Ziel dieses Workshops ist es, die Erfahrungen mit Bakterienpigmenten zu erforschen und vorzustellen und lokale Forscher, Künstler und Designer zusammenzubringen, um neue Anwendungen von Biomaterialien aus unserer Haut zu erforschen.
Wir ermutigen die Teilnehmer, alternative Wege zur Durchführung wissenschaftlicher Forschung in einem interdisziplinären Umfeld zu erkunden.
collaboration #Bioink #RapidPrototyping diy #Research #Transdisziplinarität
Der Workshop bestand aus einem Starter Kit, um unsere eigenen Hautfarben zu kultivieren und DIY-Drucke mit Bakterien zu erstellen.
Bioink Workshop wird für bis zu 5 Personen anwesend, 10 Personen online. Offen für alle, Kinder, Erwachsene, Flint/Cis gemischt. Das Kit gibt es in der Kit-Box am Eingang der Machbar/Biopunk.kitchen, ab heute oder *am Freitag davor, ab 15h Adresse: Reuterstraße 36 12047 Berlin am Eingang von "Oh la Queca "
Intro-Biohacking&Bioink Workshopaaa:
This is a short intro to biohacking and transdisciplinary design. The following hands-on workshop focuses on biomaterials, skin biome and bioink. We will mix biohacking, material science with design thinking and rapid prototyping. The aim of this workshop is to explore and introductory bacterial pigments experience and to connect local researchers, artists and designers to explore new applications of biomaterials taken from our skin. We encourage participants to explore alternative ways of conducting scientific research in an interdisciplinary setting.
collaboration #Bioink #RapidPrototyping diy #Research #Transdisciplinarity
The workshop consists of a starter kit to cultivate colours our own skin microbiota and make a DIY prints with bacteria.
Bioink workshop will be for up to 5 people presential, 10 people online. Open for everyone, children, adults, Flint/Cis mixed. The kit can be found in the kit box at the entry of Machbar/Biopunk.kitchen, from today on or *the night before Friday, from 15h Adress: 36 Reuterstraße 12047 Berlin by the entry of “Oh la Queca”